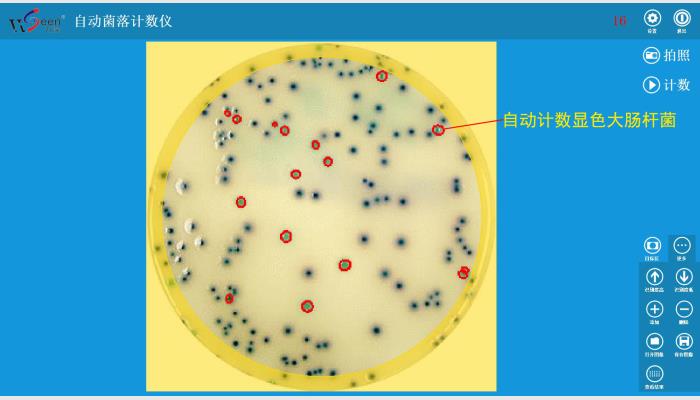

WSeen’s HiCC-B automatic colony counter
Features:
1, by a PC, the software will automatically count and output the number of colonies.
2, by adding, deleting the individual pointing correction, can make a few grains up to 100% accuracy.
3, can view the results table, export to EXCEL, and to the designated recipient to upload data.
4, highlight LED backlight device to colony count recognition more stable, can work long hours.
5, Windows system environment, user-friendly, concise, intelligent.
Technical Parameters:
1, with a 1200 megapixel color camera, the highest resolution of 0.05mm, can identify as small as 0.1mm colony
2, the backlight can be switched on imaging analysis
3, to adapt Petri dishes diameter: 50 ~120mm plate (pouring, membrane filtration, 3M paper)
4, automatic segmentation of chain or lumps of various types of colonies adhesion
5, automatic counting accuracy ≥ 96.5%, with very few amendments up to 100% correct. Analysis speed: 50 - 300 colonies / s
5, automatic removal of impurities, click on the touch screen correction, effective support for complex microbiological statistics
6, can save tens of thousands of pictures and their corresponding data, and wireless Internet to send pictures remotely, the result data
Availability list: a 1200 megapixel color camera, a software lock (under windows 10 Professional edition) and a software U disk, a LED backlight device (for DC5V), a dark field of a black film
搜索
產品類別
相關產品
- HiCC-F全自動抑菌圈測量儀、抗生素效價測定儀 >
- HICC-A2全自動菌落計數分析儀,菌落計數儀,自動菌落計數儀,菌落計數器 >
- HiCC-B1 automatic colony counter,自動菌落計數儀,菌落計數器 >
- HiCC-E型β-內酰胺酶檢驗分析儀系統,抑菌圈測量儀,抑菌圈測定儀,抗生素效價測定儀 >
- HiCC-B1型全自動菌落計數儀,菌落計數儀,自動菌落計數儀,菌落計數器 >
- HiCC-B型全自動菌落計數儀,菌落計數儀,自動菌落計數儀,菌落計數器 >
- HiCC-S1全自動菌落計數及抑菌圈測量儀系統,菌落計數儀,抑菌圈測定儀 >
- WSeen’s HiCC-B automatic colony counter >
- HiCC-D全自動菌落計數分析儀系統,菌落計數儀,自動菌落計數儀,菌落計數器 >
- HiCC-T全自動抑菌圈測量儀,抑菌圈測定儀,抗生素效價測定儀,藥敏分析儀 >
- HiCC-P型全自動抑菌圈測量儀系統,抑菌圈測定儀,抗生素效價測定儀 >
- HiCC-Z組合型全自動菌落計數、抑菌圈測量、β-內酰胺酶檢測、顯微分析儀系統 >
- HiCC-Z全自動菌落計數、抑菌圈測量、β-內酰胺酶檢驗儀 >
- HiCC-V全自動菌落計數儀、抑菌圈測量儀、細胞計數分析系統 >
- 萬深HiCC-D型全自動菌落計數分析儀 >

